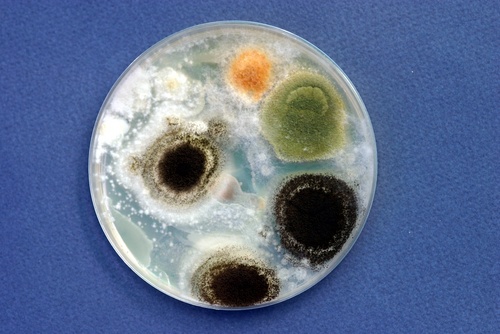

Код мкб кандидозный вагинит

Медицинский эксперт статьи
х
Весь контент iLive проверяется медицинскими экспертами, чтобы обеспечить максимально возможную точность и соответствие фактам.
У нас есть строгие правила по выбору источников информации и мы ссылаемся только на авторитетные сайты, академические исследовательские институты и, по возможности, доказанные медицинские исследования. Обратите внимание, что цифры в скобках ([1], [2] и т. д.) являются интерактивными ссылками на такие исследования.
Если вы считаете, что какой-либо из наших материалов является неточным, устаревшим или иным образом сомнительным, выберите его и нажмите Ctrl + Enter.
Кандидозный вагинит – это влагалищная инфекция, вызванная Candida spp или, наиболее часто, С. albicans. Наиболее часто кандидозный вагинит вызван С. albicans, который высевается у 15-20 % небеременных и 20-40 % беременных. Факторами риска по развитию кандидозного вагинита является диабет, использование антибиотиков широкого спектра действия или глюкокортикоидов, беременность, стягивающее нательное белье, иммунодефицитное состояние и использование внутриматочных контрацептивов. Кандидозный вагинит редок среди женщин постменопаузального периода, кроме тех, которые применяют системную гормональную терапию.
[1], [2], [3], [4], [5], [6], [7], [8], [9], [10], [11], [12]
Код по МКБ-10
B37.3 Кандидоз вульвы и вагины N77.1*
Симптомы кандидозного вагинита
Характерными симптомами и проявлениями являются влагалищный или Бульварный зуд, жжение, раздражение (которые могут усиливаться после полового контакта) и обильные, творожистые выделения, плотно налипающие на стенки влагалища. Симптомы и признаки заболевания усиливаются за неделю перед менструацией. Гиперемия, отек и трещины слизистой оболочки влагалища и вульвы являются общими симптомами заболевания. У инфицированных сексуальных партнеров могут отсутствовать признаки заболевания.
Диагностика кандидозного вагинита
Диагностическими критериями кандидозного вагинита являются: рН влагалищного секрета менее 4,5; выявление дрожжей, псевдомицелия или мицелия при проведении теста с КОН.
[13], [14], [15], [16], [17], [18], [19], [20], [21]
Какие анализы необходимы?
Лечение кандидозного вагинита
Высокоэффективно назначение вагинальных или оральных препаратов. Улучшает состояние однократное применение флуконазола в дозе 150 мг внутрь. Эффективно применение фармацевтических препаратов бутоконазола, клотримазола, миконазола и тиоконазола для местного использования. Однако пациенты должны быть предупреждены, что влагалищные кремы и мази, содержащие минеральное или растительное масло, разрушают презервативы на основе латекса.
Если симптомы сохраняются или течение заболевания ухудшается при проведении местной терапии, необходимо исключить аллергическую реакцию к местным противогрибковым препаратам. Рецидивы заболевания отмечаются редко. Частые рецидивы требуют назначения отдаленной терапии оральными препаратами: флуконазол 150 мг еженедельно в течение месяца или кетоконазол 100 мг 1 раз в день.
Препараты для лечения кандидозного вагинита
Тип | Лекарственное средство | Доза |
Препараты для местного применения | Бутоконазол | 2 % крем 5 г 1 раз в день в течение 3 дней, 2 % крем 5 г для однократной апликации |
Клотримазол | 1 %крем5г1 раз в день в течение 7-14 дней. Влагалищные таблетки 100 мг 1 раз в день в течение 7 дней, или 200 мг 1 раз в день в течение 3 дней, или 500 мг однократно | |
Миконазол | 2 % крем 5 г 1 раз в день в течение 7 дней. Влагалищные свечи 100 мг 1 раз в день в течение 7 дней или 200 мг 1 раз в день в течение 3 дней | |
Нистатин | Влагалищные таблетки 100 000 ЕД1 раз в день в течение 14 дней | |
Терконазол | 0,4 % крем 5 г 1 раз в день в течение 7 дней или 0,8 % крем 5 г 1 раз в день в течение Здней. Влагалищные свечи 80 мг 1 раз в день в течение 3 дней | |
Тиоконазол | 6,5 % мазь 5 г однократно | |
Для внутреннего применения | Флуконазол | 150 м г однократно |
Источник
Связанные заболевания и их лечение
Описания заболеваний
Национальные рекомендации по лечению
Содержание
- Описание
- Причины
- Симптомы
- Диагностика
- Лечение
- Профилактика
- Основные медицинские услуги
- Клиники для лечения
Названия
Кандидоз влагалища.
Рост грибков Candida в лабораторных условиях
Описание
Молочница (кандидозный кольпит, кандидоз влагалища) – это аболевание влагалища воспалительной природы, этиологическим агентом для которого служит грибковая инфекция. Молочница склонна к частому рецидивированию на фоне снижения иммунитета. Около 5% заболевших отмечают рецидив заболевания чаще, чем 1 раз в квартал.
Причины
Молочница развивается чаще в период перед менструацией. Огромную роль играет снижение местного иммунитета слизистой оболочки влагалища.
Ограниченное количество дрожжевидных грибков живет в организме человека при физиологическим условиях. Слизистые оболочки полости рта, желудочно-кишечной системы, влагалища – их обычная среда обитания. При молочнице их количество резко возрастает, что обуславливает воспалительную реакцию.
Установлено, что причиной молочницы служат грибки рода Candida albicans В норме рост грибковой флоры сдерживается лактобактериями. Однако, при нарушении баланса микрофлоры, дрожжевидные грибки легко размножаются, вызывая патологически процесс. Многие заболевшие отмечают связь появления или рецидива молочницы на фоне приема антибиотиков, что и объясняется пагубным воздействием лекарств на микрофлору влагалища.
Выделено множество факторов, под воздействием которых повышается риск развития молочницы:
- прием гормональной терапии.
- беременность.
- вторичный и первичный иммунодефицит.
- интеркуррентные заболевания, в первую очередь, сахарный диабет.
- нарушение правил личной гигиены.
- ношение синтетического белья и тесных брюк.
Благоприятным условием для размножения грибковой флоры является влажная среда. Именно поэтому после купания в водоеме и занятий спортом следует как можно быстрее сменить белье. Не лучшим способом влияет на микрофлору влагалища гигиенических прокладок и тампонов с отдушинами, а также ароматизированной туалетной бумаги.
Рецидивы заболевания объясняются особой реакций организма – гиперчувствительностью к грибкам рода Candida.
Не следует забывать о механизме передачи инфекции от матери к ребенку как при естественных родах, так и после кесарева сечения.

Грибковое поражение слизистых оболочек
Симптомы
Симптомы молочницы довольно характерны и известны многих женщинам. Первыми жалобами является зуд или чувство жжения во влагалище, затем появляются влагалищные выделения. Выделения могут быть необильными и не иметь запаха, однако чаще всего они густые, творожистые, в виде хлопьев.
Одним из важных признаков является усиление зуда после гигиенических процедур, в вечернее время. Интенсивность зуда бывает настолько велика, что мешает уснуть.
Существенным симптомом молочницы является болезненность при половом акте.
Молочница вызывает дискомфорт и, вследствие этого, снижает качество жизни. Кроме того, под маской молочницы могут скрываться другие, более серьезные заболевания – эндометрит и сальпингит.
Вагинальный кандидоз при беременности предполагает повышенный риск самопроизвольного аборта и внутриутробного инфицирования плода.
Диагностика
Кроме клинический проявлений, в диагностике молочницы играет лабораторное обследование.
При микроскопическом исследовании мазка влагалищных выделений диагностируются дрожжевидные грибки, часто в виде псевдомицелия и бластоспор. Бессимптомное кандидоносительство, выявляемое у 60% женщин, проявляется обнаружением лишь бластоспор.
Хронические и рецидивирующие формы молочницы предполагают культурального метода исследования, включая определение чувствительности к антимикозной терапии. С этой целью удобны в применении готовые тест-системы «Фунги-тест» и «Кандиселект».
Диагностика кандидоза безприборным методом возможна по анализу мочи с помощью применения Литос-системы.
Лечение
Основа лечения молочницы – это комбинирование противовоспалительных и противогрибковых препаратов.
Противогрибковые препараты применяются в форме таблеток, капсул, вагинальных свечей и кремов. Действующие вещества вагинальных кремов и свечей: миконазол, клотримазол, тиоконазол и другие. Вагинальные кремы продаются в упаковке со специальными аппликаторами, что существенно облегчает их использование. Кроме того, при помощи аппликатора можно обрабатывать область наружных половых органов, которая также может быть поражена при молочнице.
Современные таблетированные противогрибковые препараты обладают высокой эффективностью и безопасностью действия. Доза препарата, скрытая всего в одной капсуле, способна купировать острый, незапущенный кандидоз влагалища.
Эти препараты применяются курсом согласно инструкции к препарату. Очень важно завершить курс лечения до конца, даже если симптомы молочницы исчезли раньше.
Профилактика
Меры профилактики молочницы довольно просты в исполнении. В первую очередь, необходимо обратить внимание на нижнее белье – оно должно быть из натуральных тканей. Натуральность ткани приветствуется при выборе и одежды.
Выполняя гигиенические процедуры, не забывайте о правильности использования салфеток в направлении от влагалища к анальному отверстию, чтобы избежать заражения кишечной флорой. Выбирая гигиенические прокладки, тампоны и салфетки, остановите свой выбор на неароматизированных. Помните, что гигиенические прокладки подлежат смене каждые 3-4 часа. При половом акте используйте презерватив, который предохранит не только от СПИДа, венерических заболеваний, но и от молочницы.
Основные медуслуги по стандартам лечения | ||
Клиники для лечения с лучшими ценами
|
Источник
Связанные заболевания и их лечение
Описания заболеваний
Национальные рекомендации по лечению
Содержание
- Описание
- Причины
- Симптомы
- Диагностика
- Лечение
- Профилактика
- Основные медицинские услуги
- Клиники для лечения
Названия
Кандидоз влагалища.

Рост грибков Candida в лабораторных условиях
Описание
Молочница (кандидозный кольпит, кандидоз влагалища) – это аболевание влагалища воспалительной природы, этиологическим агентом для которого служит грибковая инфекция. Молочница склонна к частому рецидивированию на фоне снижения иммунитета. Около 5% заболевших отмечают рецидив заболевания чаще, чем 1 раз в квартал.
Причины
Молочница развивается чаще в период перед менструацией. Огромную роль играет снижение местного иммунитета слизистой оболочки влагалища.
Ограниченное количество дрожжевидных грибков живет в организме человека при физиологическим условиях. Слизистые оболочки полости рта, желудочно-кишечной системы, влагалища – их обычная среда обитания. При молочнице их количество резко возрастает, что обуславливает воспалительную реакцию.
Установлено, что причиной молочницы служат грибки рода Candida albicans В норме рост грибковой флоры сдерживается лактобактериями. Однако, при нарушении баланса микрофлоры, дрожжевидные грибки легко размножаются, вызывая патологически процесс. Многие заболевшие отмечают связь появления или рецидива молочницы на фоне приема антибиотиков, что и объясняется пагубным воздействием лекарств на микрофлору влагалища.
Выделено множество факторов, под воздействием которых повышается риск развития молочницы:
- прием гормональной терапии.
- беременность.
- вторичный и первичный иммунодефицит.
- интеркуррентные заболевания, в первую очередь, сахарный диабет.
- нарушение правил личной гигиены.
- ношение синтетического белья и тесных брюк.
Благоприятным условием для размножения грибковой флоры является влажная среда. Именно поэтому после купания в водоеме и занятий спортом следует как можно быстрее сменить белье. Не лучшим способом влияет на микрофлору влагалища гигиенических прокладок и тампонов с отдушинами, а также ароматизированной туалетной бумаги.
Рецидивы заболевания объясняются особой реакций организма – гиперчувствительностью к грибкам рода Candida.
Не следует забывать о механизме передачи инфекции от матери к ребенку как при естественных родах, так и после кесарева сечения.

Грибковое поражение слизистых оболочек
Симптомы
Симптомы молочницы довольно характерны и известны многих женщинам. Первыми жалобами является зуд или чувство жжения во влагалище, затем появляются влагалищные выделения. Выделения могут быть необильными и не иметь запаха, однако чаще всего они густые, творожистые, в виде хлопьев.
Одним из важных признаков является усиление зуда после гигиенических процедур, в вечернее время. Интенсивность зуда бывает настолько велика, что мешает уснуть.
Существенным симптомом молочницы является болезненность при половом акте.
Молочница вызывает дискомфорт и, вследствие этого, снижает качество жизни. Кроме того, под маской молочницы могут скрываться другие, более серьезные заболевания – эндометрит и сальпингит.
Вагинальный кандидоз при беременности предполагает повышенный риск самопроизвольного аборта и внутриутробного инфицирования плода.
Диагностика
Кроме клинический проявлений, в диагностике молочницы играет лабораторное обследование.
При микроскопическом исследовании мазка влагалищных выделений диагностируются дрожжевидные грибки, часто в виде псевдомицелия и бластоспор. Бессимптомное кандидоносительство, выявляемое у 60% женщин, проявляется обнаружением лишь бластоспор.
Хронические и рецидивирующие формы молочницы предполагают культурального метода исследования, включая определение чувствительности к антимикозной терапии. С этой целью удобны в применении готовые тест-системы «Фунги-тест» и «Кандиселект».
Диагностика кандидоза безприборным методом возможна по анализу мочи с помощью применения Литос-системы.
Лечение
Основа лечения молочницы – это комбинирование противовоспалительных и противогрибковых препаратов.
Противогрибковые препараты применяются в форме таблеток, капсул, вагинальных свечей и кремов. Действующие вещества вагинальных кремов и свечей: миконазол, клотримазол, тиоконазол и другие. Вагинальные кремы продаются в упаковке со специальными аппликаторами, что существенно облегчает их использование. Кроме того, при помощи аппликатора можно обрабатывать область наружных половых органов, которая также может быть поражена при молочнице.
Современные таблетированные противогрибковые препараты обладают высокой эффективностью и безопасностью действия. Доза препарата, скрытая всего в одной капсуле, способна купировать острый, незапущенный кандидоз влагалища.
Эти препараты применяются курсом согласно инструкции к препарату. Очень важно завершить курс лечения до конца, даже если симптомы молочницы исчезли раньше.
Профилактика
Меры профилактики молочницы довольно просты в исполнении. В первую очередь, необходимо обратить внимание на нижнее белье – оно должно быть из натуральных тканей. Натуральность ткани приветствуется при выборе и одежды.
Выполняя гигиенические процедуры, не забывайте о правильности использования салфеток в направлении от влагалища к анальному отверстию, чтобы избежать заражения кишечной флорой. Выбирая гигиенические прокладки, тампоны и салфетки, остановите свой выбор на неароматизированных. Помните, что гигиенические прокладки подлежат смене каждые 3-4 часа. При половом акте используйте презерватив, который предохранит не только от СПИДа, венерических заболеваний, но и от молочницы.
Основные медуслуги по стандартам лечения | ||
Клиники для лечения с лучшими ценами
|
Источник
Утратил силу — Архив
Также:
PN-O-002
РЦРЗ (Республиканский центр развития здравоохранения МЗ РК)
Версия: Архив – Клинические протоколы МЗ РК – 2007 (Приказ №764)
Категории МКБ:
Другие уточненные воспалительные болезни влагалища и вульвы (N76.8)
Общая информация
Краткое описание
Кольпит – воспаление слизистой оболочки влагалища, вызванное различными микроорганизмами.
Код протокола: PN-O-002 “Кольпит”
Профиль: акушерско-гинекологический
Этап: ПМСП (медицинский пункт)
Код (коды) по МКБ-10: N 76 Другие виды воспаления влагалища и вульвы
Облачная МИС “МедЭлемент”
Облачная МИС “МедЭлемент”
Классификация
1. Кандидозный вагинит.
2. Бактериальный вагиноз.
3. Атрофический вагинит.
4. Трихомониаз.
Факторы и группы риска
1. Молодой возраст.
2. Частая смена половых партнеров.
3. Множество половых партнеров.
4. Плохие социально-экономические условия.
5. Низкий образовательный уровень.
6. Раннее начало половой жизни.
7. Влагалищные спринцевания.
8. Внутриматочная контрацепция как возможный источник осложнений.
Диагностика
Диагностические критерии:
1. Зуд, жжение, боли, гнойные, пенистые выделения из влагалища.
2. Запах.
3. Гиперемия, отек, петехиальные высыпания на слизистой оболочке влагалища и шейки матки.
4. Повышенное количество лейкоцитов (более 20 в поле зрения) и другая патологическая микрофлора в мазке из влагалища.
Перечень основных диагностических мероприятий:
1. Тест с гидроксидом калия: нанести несколько капель гидроксида калия на влагалищное зеркало, при наличии бактериального вагиноза появляется сильный рыбный запах.
2. Микроскопическое исследование мазка (содержание лейкоцитов более 20 в поле зрения).
Онлайн-консультация врача
Посоветоваться с опытным специалистом, не выходя из дома!
Консультация по вопросам здоровья от 2500 тг / 430 руб
Интерпретация результатов анализов, исследований
Второе мнение относительно диагноза, лечения
Выбрать врача
Лечение
Тактика лечения
Установлено, что чаще всего кольпит вызывают грибковые возбудители, трихоманады, гарднереллы. В связи с чем необходимо лечение препаратами широкого спектра (тинидазолы – метронидазол), в течение 5-7 дней.
Эффективность лечения повышается при совместном лечении обоих половых партнеров. В I триместре беременности использование тинидазолов противопоказано в связи с наличием тератогенных эффектов. Во время беременности (после 12 недель) – местные аппликации 2% крема с клиндамицином.
Перечень основных медикаментов (по назначению врача акушер-гинеколога):
1. *Метронидазол 250 мг табл.
2. Клотримазол (вагинальные таблетки) 100 мг табл.
3. *Итраконазол оральный раствор 150 мл – 10 мг/мл
Перечень дополнительных медикаментов:
1. Клиндамицин 10 мг гель для наружного применения
Показания для госпитализации: неэффективность лечения в течение 7 дней.
Индикаторы эффективности лечения: нормализация показателей мазка.
* – препараты, входящие в список основных (жизненно важных) лекарственных средств
Информация
Источники и литература
- Протоколы диагностики и лечения заболеваний МЗ РК (Приказ №764 от 28.12.2007)
- Список использованной литературы:
1. National Guideline Clearinghouse: Common Gynecologic Problems: a Guide to Diagnosis
and Treatment 2002.- www.guideline.gov
2. National Guideline Clearinghouse: 2002 National Guideline on the Managment of
Trichomonas Vaginalis.- www.guideline.gov
3. Инфекционные заболевания в акушерстве и гинекологии.- Ярославль.- 2003.- с.31
4. Инфекции, передающиеся половым путем.- Ярославль.- 2000.- с.51
5. Institute for Clinical Systems Improvement. Health Care Guideline. Rutine Prenatal Care,
2005, p.80
6. National Collaborating Center for Women’s and Children’s Health. Antenatal Care: Rutine
Care for the Healthy Pregnant Women. Clinical Guideline, 2003, p.286
- Список использованной литературы:
Информация
Список разработчиков: Утегалиева Г.Н., Республиканский Медицинский Колледж
Прикреплённые файлы
Мобильное приложение “MedElement”
- Профессиональные медицинские справочники. Стандарты лечения
- Коммуникация с пациентами: онлайн-консультация, отзывы, запись на приём
Скачать приложение для ANDROID / для iOS
Мобильное приложение “MedElement”
- Профессиональные медицинские справочники
- Коммуникация с пациентами: онлайн-консультация, отзывы, запись на приём
Скачать приложение для ANDROID / для iOS
Внимание!
Если вы не являетесь медицинским специалистом:
- Занимаясь самолечением, вы можете нанести непоправимый вред своему здоровью.
- Информация, размещенная на сайте MedElement и в мобильных приложениях “MedElement (МедЭлемент)”, “Lekar Pro”,
“Dariger Pro”, “Заболевания: справочник терапевта”, не может и не должна заменять очную консультацию врача.
Обязательно
обращайтесь в медицинские учреждения при наличии каких-либо заболеваний или беспокоящих вас симптомов.
- Выбор лекарственных средств и их дозировки, должен быть оговорен со специалистом. Только врач может
назначить
нужное лекарство и его дозировку с учетом заболевания и состояния организма больного.
- Сайт MedElement и мобильные приложения “MedElement (МедЭлемент)”, “Lekar Pro”,
“Dariger Pro”, “Заболевания: справочник терапевта” являются исключительно информационно-справочными ресурсами.
Информация, размещенная на данном
сайте, не должна использоваться для самовольного изменения предписаний врача.
- Редакция MedElement не несет ответственности за какой-либо ущерб здоровью или материальный ущерб, возникший
в
результате использования данного сайта.
Источник
